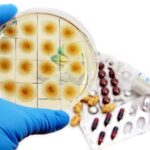

| ||||||||||||||||||
| Dilluns | Dimarts | Dimecres | Dijous | Divendres | Dissabte | Diumenge | ||||||||||||
1Com utilitzar els programaris per optimitzar processosCom utilitzar els programaris per optimitzar processosTime: 9:30 - 11:00 Continguts: Una jornada per reflexionar sobre els factors que limiten la productivitat de les empreses. S'aportaran nous punts de vista i solucions a aquestes problemàtiques. Una jornada impartida per Albert Cugat, consultor de software i Jordi Ferrando, CEO d'Infordisa /// Dia: Dijous 1 de desembre del 2022/// Hora: 9:30 hores/// Presencial: Sala Actes Cambra de Valls/// Sessió: gratüita/// Inscripcions: https://forms.gle/48ZPYWWjo7kjrWUd6/// Continguts: Una jornada per reflexionar sobre els factors que limiten la productivitat de les empreses. S'aportaran nous punts de vista i solucions a aquestes problemàtiques. Una jornada impartida per Albert Cugat, consultor de software i Jordi Ferrando, CEO d'Infordisa /// Dia: Dijous 1 de desembre del 2022/// Hora: 9:30 hores/// Presencial: Sala Actes Cambra de Valls/// Sessió: gratüita/// Inscripcions: https://forms.gle/48ZPYWWjo7kjrWUd6///
| 2 | 3 | 4 | |||||||||||||||
| 5 | 6 | 7 | 8 | 9 | 10 | 11 | ||||||||||||
| 12 | 13 | 14Curs teòric pràctic: Renovació Oficial de legionel·laCurs teòric pràctic: Renovació Oficial de legionel·la Continguts: Actualització normativa de la legislació nacional i autonòmica en relació amb la legionel·la, prevenció de riscos laborals i mediambientals./// Calendari del curs: dimecres 14 i dijous 15 de desembre/// Durada: 10 hores/// Horari: de 15 a 20h/// Lloc impartició: Grup Cief Reus/// Inscripcions: formacio@cambravalls.com/// Programa: https://cambravalls.com/wp-content/uploads/2022/11/Legionella-Renovacio-certif.-Oficial-14.12.2022.pdf///
Com accedir als ajuts per digitalitzar el teu negociCom accedir als ajuts per digitalitzar el teu negociTime: 16:00 - 17:00 Continguts: Actualització normativa de la legislació nacional i autonòmica en relació amb la legionel·la, prevenció de riscos laborals i mediambientals./// Calendari del curs: dimecres 14 i dijous 15 de desembre/// Durada: 10 hores/// Horari: de 15 a 20h/// Lloc impartició: Grup Cief Reus/// Inscripcions: formacio@cambravalls.com/// Programa: https://cambravalls.com/wp-content/uploads/2022/11/Legionella-Renovacio-certif.-Oficial-14.12.2022.pdf///
Com accedir als ajuts per digitalitzar el teu negociCom accedir als ajuts per digitalitzar el teu negociTime: 16:00 - 17:00 Continguts: Vine a la propera jornada organitzada per la Cambra de Comerç de Valls i esbrina què és el Kit Digital i com el vostre negoci pot beneficiar-se dels ajuts per a la digitalització. També us donarem a conèixer nous ajuts i subvencions entorn la Indústria 4.0 que s’obriran en breu. Una jornada que compta amb el suport de red.es, la Cámara de Comercio de España i la Unió Europea./// Dia: Dimecres 14 de desembre del 2022/// Hora: 16:00 hores/// Presencial: Cambra Comerç de Valls/// Sessió: gratuita/// Inscripcions: https://forms.gle/Px8WziEMaMwMYKR86/// Continguts: Vine a la propera jornada organitzada per la Cambra de Comerç de Valls i esbrina què és el Kit Digital i com el vostre negoci pot beneficiar-se dels ajuts per a la digitalització. També us donarem a conèixer nous ajuts i subvencions entorn la Indústria 4.0 que s’obriran en breu. Una jornada que compta amb el suport de red.es, la Cámara de Comercio de España i la Unió Europea./// Dia: Dimecres 14 de desembre del 2022/// Hora: 16:00 hores/// Presencial: Cambra Comerç de Valls/// Sessió: gratuita/// Inscripcions: https://forms.gle/Px8WziEMaMwMYKR86///
| 15 | 16 | 17 | 18 | ||||||||||||
| 19 | 20 | 21 | 22 | 23 | 24 | 25 | ||||||||||||
| 26 | 27 | 28 | 29 | 30 | 31 | |||||||||||||
| ||||||||||||||||||
Pròxims esdeveniments
- 31 de març de 2026
- Workshop: Com utilitzar les solucions del kit digital per integrar la IA al teu negoci i guanyar eficiència?
 La Cambra de Comerç de Valls organitza un workshop pràctic sobre com integrar la IA al negoci amb el Kit Digital. Sessió orientada a autònoms i pimes, amb creació d’un chatbot aplicat a la gestió comercial i explicació de les subvencions disponibles. Amb la participació de Pau Esteve, CEO i founder de Soul Phygital./// Dia: dimarts 31 de març de 2026./// Hora: de 9 a 11:20 hores./// Lloc: sala d'actes de la Cambra de Comerç de Valls./// Enllaç inscripció: https://forms.office.com/e/rhzG0wXDqu///Descarrega el programa: https://cambravalls.com/wp-content/uploads/2026/03/WORKSHOP-PAU-ESTEVE-2026.pdf///
La Cambra de Comerç de Valls organitza un workshop pràctic sobre com integrar la IA al negoci amb el Kit Digital. Sessió orientada a autònoms i pimes, amb creació d’un chatbot aplicat a la gestió comercial i explicació de les subvencions disponibles. Amb la participació de Pau Esteve, CEO i founder de Soul Phygital./// Dia: dimarts 31 de març de 2026./// Hora: de 9 a 11:20 hores./// Lloc: sala d'actes de la Cambra de Comerç de Valls./// Enllaç inscripció: https://forms.office.com/e/rhzG0wXDqu///Descarrega el programa: https://cambravalls.com/wp-content/uploads/2026/03/WORKSHOP-PAU-ESTEVE-2026.pdf///
- Workshop: Com utilitzar les solucions del kit digital per integrar la IA al teu negoci i guanyar eficiència?
- 8 d'abril de 2026
- Curs: Excel avançat
 Objectiu del curs: Aprendràs a dominar funcions avançades d’Excel per analitzar dades i crear informes professionals; utilitzar fórmules com BUSCARV, BUSCARX, SI o SI.CONJUNT; aplicar funcions de data, text i lògica per netejar i transformar dades; crear taules dinàmiques i gràfics avançats per visualitzar informació; i elaborar informes i dashboards per detectar tendències i oportunitats./// Dies: Dillun si dimecres 8, 13, 15 i 20 d'abril de 2026./// Horari: de 17 a 20 hores./// Lloc: Cambra de Comerç de Valls./// Inscripcions: formacio@cambravalls.com ///
Objectiu del curs: Aprendràs a dominar funcions avançades d’Excel per analitzar dades i crear informes professionals; utilitzar fórmules com BUSCARV, BUSCARX, SI o SI.CONJUNT; aplicar funcions de data, text i lògica per netejar i transformar dades; crear taules dinàmiques i gràfics avançats per visualitzar informació; i elaborar informes i dashboards per detectar tendències i oportunitats./// Dies: Dillun si dimecres 8, 13, 15 i 20 d'abril de 2026./// Horari: de 17 a 20 hores./// Lloc: Cambra de Comerç de Valls./// Inscripcions: formacio@cambravalls.com ///
- Curs: Excel avançat
Avui en curs
Avui no hi ha esdeveniments
Històric d'esdeveniments
Acord entre la Cambra de Valls i educació per ampliar i potenciar les estades dels alumnes de FP a les empreses de la demarcació

Jornada: Port Tarragona: Motor metropolità
Informació

Webinar: Conscienciació en seguretat informàtica
Informació

TALENTO 45+: Curs electricitat industrial
Informació

Curs: Excel & IA
Informació

CURS: Emprenedors 360º
Informació

JORNADA: L'adaptació dels programes formatius de la FP Dual com a oportunitat per les empreses
Informació

Webinar aceleraPime: domina els marketplace del futur
Informació

WEBINAR ACCELRA PIME: Construeix una marca personal
Informació

WEBINAR ACCELERA PIME: Digitalització i optimització
Informació

ACCELERA PIME: La IA aplicada a les empreses
Informació

JORNADA ACELERA PIME: La digitalització en PRL i RRHH
Informació

JORNADA ACELERA PIME: Web Scraping
Informació

JORNADA: Productivitat i IA per a pimes
Informació

webinar: Vols sol·licitar el Kit Digital? T'ajudem!
Informació

Informe de Conjuntura Econòmica 1r Trimestre del 2024
Informació

WEBINAR ACCELERAPIME: Blockchain industrial
Informació

WEBINAR: xarxes socials i dades sobre audiència
Informació

WEBINAR ACELERAPIME: Big data i anàlisi de dades
Informació

JORNADA ACCELERAPIME: Núvol i col·laboració
Informació

WEBINAR ACELERAPIME: Ecommerce des de zero
#internacionalInformació

WEBINAR ACELERAPIME: Connecta amb el teu client!
Informació

webinar: Vols digitalitzar la teva empresa?
Informació

(copy) webinar: Vols digitalitzar la teva empresa?
Informació

webinar: La Llei Crea i Creix i la factura electrònica
Informació

webinar: Solució amb IA a la Llei Crea i Creix
Informació

webinar: canal de denúncies per empreses
Informació
Curs de gestió avançada de comerç internacional amb la Cambra de Valls
#internacional
webinar: Què ofereix Bizum com a mètode de pagament
Informació

webinar: Google Calendar, tasks boars, keep notes
Informació

Jornada: Llatinoamèrica, una regió per explorar
Informació

webinar: whatsapp Business per a professionals
Informació
Sessió informativa del curs d'activitats auxiliars en vivers, jardins i centres de jardineria

webinar: Quins beneficis aporta la gestió per processos?
Informació

Com utilitzar els programaris per optimitzar processos
Informació

Com accedir als ajuts per digitalitzar el teu negoci
Informació

Xarxes Socials per ser més visibles i vendre més
Informació

El blockchain com a eina de competitivitat de l'empresa
Informació

3 coses que has de saber dels ciberatacs
Informació

Presentació Oficina Acelera pyme Cambra valls
Informació

Eines bàsiques de MKT digital per connectar amb el client
Informació
La Cambra de Comerç, Indústria i Serveis de Valls serà present a la 22a edició de l'Espai de l'Estudiant

La meva empresa pot accedir a finançaments de Fons Europeus?
Informació
Jornada. OBJECTIU 2016: EL PROTOCOL FAMILIAR. Dimarts 7 de juny a les 19:00h.
Llegiu-ne més
Jornada: M'HE DE PREOCUPAR PER LA NORMATIVA ADR? - Dimecres 8 de juny a les 10:00
#internacionalLlegiu-ne més
Jornada - AFRONTAR AMB ÈXIT EL SEGON I SUCCESSIUS CANVIS PROFESSIONALS
Llegiu-ne més
Curs CARRETONERS ELEVADORS - Frontal i Retràctil
Llegiu-ne més
Jornada - Repercussions de la reforma del Codi Penal
Llegiu-ne més
SEMINARI "FISCALITAT DE L'EMPRESA" - DIJOUS 15.10.2015 A LES 16:00H
Curs Superior en DISSENY, UTILLATGE I PROCESSOS PLÀSTICS
Llegiu-ne més
Curs XINÈS BÀSIC II
Llegiu-ne més
Curs PRIMERS AUXILIS I INSTAL.LACIÓ I ÚS DE DESFIBRIL.LADORS
Llegiu-ne més
XIII Jornada Gresol a Valls - Dimecres 8 d'octubre
Llegiu-ne més
Celebració del curs d'ICOTERMS
#internacionalLlegiu-ne més
Curs INCOTERMS 2010: Novetats i Correcta Utilització
#internacionalLlegiu-ne més
Curs CARRETONERS FRONTAL
Llegiu-ne més
Jornada c-OFFICE - Camerfirma - Djous 10 Abril
Llegiu-ne més
Curs XINÈS II - del 28 d'abril al 18 de juny
Llegiu-ne més
Curs - SISTEMA FISCAL - Actualitzacions (abril-juny)
Llegiu-ne més
SEMINARI SOBRE EL TRACTAMENT D’INCIDÈNCIES EN EL TRANSPORT INTERNACIONAL
#internacionalLlegiu-ne més
JORNADA "COM GESTIONAR PERSONES PER MILLORAR ELS RESULTATS DE L'EMPRESA
SEMINARI SOBRE EL TRACTAMENT D’INCIDÈNCIES EN EL TRANSPORT INTERNACIONAL
#internacionalLlegiu-ne més
JORNADA "COM GESTIONAR PERSONES PER MILLORAR ELS RESULTATS DE L'EMPRESA
















